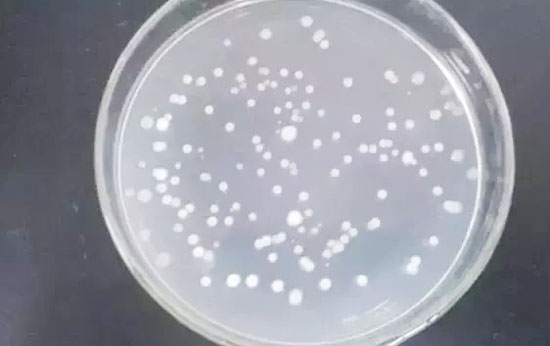

微生物肥料之所以比有機肥貴,是因為添加了生物活性菌!所以菌種的作用對于微生物肥料來說是最重要的。目前市場上的微生物肥料菌種添加主要都以枯草芽孢桿菌為主,所以了解枯草芽孢桿菌的作用非常重要,今天我們就一起來看看!
枯草芽孢桿菌的作用包括:
1、抗生作用
抗生作用是指拈抗微生物通過產(chǎn)生代謝產(chǎn)物在低濃度下就能夠?qū)Σ≡⑸锏纳L和 代謝產(chǎn)生抑制作用,從而來影響病原微生物的生存和活動。近半個世紀以來,人們從枯草芽孢桿菌不同菌株的代謝產(chǎn)物中分離純化了多種有效的抗菌物質(zhì)。


2、誘導(dǎo)植物產(chǎn)生抗性及促進植物生長
誘導(dǎo)植物產(chǎn)生抗性作用是指枯草芽孢桿菌不但能夠抑制植物病原菌,而且還能夠誘 發(fā)植物自身抗病機制從而增強植物的抗病性能的作用。
其中以枯草芽孢桿菌的抗逆性最強、功能最多、適應(yīng)性最廣、效果最穩(wěn)定。枯草芽孢桿菌能夠產(chǎn)生類似細胞分裂素、植物生長激素的物質(zhì),促進植物的生長使植物抵抗病原菌的侵害。
3、溶菌作用
枯草芽孢桿菌的溶菌作用主要表現(xiàn)在是通過吸附在病原菌的菌絲上,并隨著菌絲生長 而生長,而后產(chǎn)生溶菌物質(zhì)造成原生質(zhì)泄露使得菌絲體斷裂;或者是產(chǎn)生抗菌物質(zhì)通過溶解病原菌孢子的細胞壁或細胞膜,致使細胞壁穿孔、畸形等現(xiàn)象從而抑制孢子萌發(fā)。
4、保護環(huán)境
枯草芽孢桿菌大量應(yīng)用于生物肥料。當(dāng)作用于作物或土壤時,能夠在作物根際或體內(nèi)定殖,并起到特定肥料效應(yīng)。目前,微生物肥料在培肥地力,提高化肥利用率,抑制農(nóng)作物對硝態(tài)氮、重金屬、農(nóng)藥的吸收,凈化和修復(fù)土壤,降低農(nóng)作物病害發(fā)生,促進農(nóng)作物秸稈和城市垃圾的腐熟利用。提高農(nóng)作物產(chǎn)品品質(zhì)和食品安全等方面表現(xiàn)出了不可替代的作用。

5、影響植物的氣空開閉
在高濃度鹽類作用下, 氣孔保衛(wèi)細胞內(nèi)的淀粉形成受到阻礙, 使細胞不能關(guān)閉,植物容易干旱枯萎。選擇耐鹽的巨大芽孢桿菌和枯草芽孢桿菌優(yōu)勢菌株,生產(chǎn)出生物有機肥,用于植物生產(chǎn),在投入成本相同的情況下,植物生長發(fā)育良好,產(chǎn)量增加,而且鹽堿地土壤理化性狀得到改善,土壤微生物數(shù)量增多。此外由于枯草芽孢桿菌無致病性, 并可以分泌多種酶和抗生素, 而且還具有良好的發(fā)酵 基礎(chǔ),所以用途十分廣泛。
6、枯草芽孢桿菌對土壤微生物的呼吸強度的影響
土壤呼吸強度作為土壤生物活性指標之一,能夠在一定程度上反應(yīng)土壤營養(yǎng)物的轉(zhuǎn)化和供應(yīng)能力,其呼吸速率變化及變化方向也反應(yīng)了生態(tài)系統(tǒng)對脅迫的敏感程度和響應(yīng)模式,是環(huán)境安全評價的一項重要指標,當(dāng)土壤受到外來污染物污染時,微生物為了維持生存可能需要更多的能量,而使土壤微生物的代謝活性發(fā)生不同程度的響應(yīng)。研究表明各質(zhì)量分數(shù)處理的枯草芽孢桿菌均表現(xiàn)為對土壤呼吸作用的刺激效應(yīng),并且土壤中枯草芽孢桿菌質(zhì)量分數(shù)越大,對土壤呼吸強度的刺激作用越大,即刺激強度和施藥質(zhì)量分數(shù)呈正相關(guān)。
7、枯草芽孢桿菌對土壤脲酶活性的影響
應(yīng)用土壤酶作為監(jiān)測指標,評價農(nóng)藥的生態(tài)毒理效應(yīng)已成為環(huán)境科學(xué)領(lǐng)域的研究熱點之一。而脲酶屬于土壤中研究得比較深入的一種水解酶類,是惟一對尿素在土壤中轉(zhuǎn)化及尿素利用率有重大影響的酶。
尿素施人土壤后,在脲酶的催化作用下,迅速分解成二氧化碳和氨,所以土壤脲酶活性的降低,不僅可使尿素水解減緩,令其水解產(chǎn)物更多地被土壤吸附而有效減少尿素水解產(chǎn)物氨的揮發(fā)損失,也可能相應(yīng)減少水解產(chǎn)物NH硝化作用潛勢。
研究表明所有處理用枯草芽孢桿菌處理過的土壤對土壤脲酶均表現(xiàn)出刺激效應(yīng)。其中最高質(zhì)量分數(shù)處理(3200mg/kg干土)在第28天脲酶活性上升到最高,刺激率達到101.07%。枯草芽孢桿菌對脲酶刺激的機理,可能是由于微生物農(nóng)藥的加人為微生物的生長提供了碳源和營養(yǎng),從而使產(chǎn)生該種酶的微生物數(shù)量增長,活性增強,因而土壤中脲酶的活性也相應(yīng)增強。

8、枯草芽孢桿菌對鹽堿地的改良
土壤內(nèi)鹽分積累的危害 土壤結(jié)構(gòu)黏滯,通氣性差,容重高,土溫上升,好氣性微生物活動差,養(yǎng)分釋放慢,滲透系數(shù)低,毛細作用強等,導(dǎo)致表層土壤鹽漬化進一步加劇,造成土壤冷、硬、板現(xiàn)象。一般說來,當(dāng)土壤表層或亞表層中的水溶性鹽類累積累超過0.1%,或土壤堿化層的堿化度超過5%,就屬于鹽漬土。
9、影響植物正常營養(yǎng)吸收
由于交換性Na+的競爭,使植物對鉀、磷和其他營養(yǎng)元素的吸收減少,磷的轉(zhuǎn)移也會受到抑制,從而影響植物的營養(yǎng)狀況。
10.、引起植物的生理干旱
過多的可溶性鹽類,可提高土壤溶液的滲透壓,引起植物的干旱。
11、 危害植物組織
干旱季節(jié),表土層鹽分過量積聚易傷下胚軸。在高pH值下,還會導(dǎo)致OH 一對植物的直接毒害。植物組織內(nèi)鹽分過量積聚,會使原生質(zhì)受害,蛋白質(zhì)合成受阻,含氮的中間代謝產(chǎn)物積累,造成細胞中毒。

12、枯草芽孢桿菌對土壤中的菲與苯并芘的吸附及生物降解功能
土壤與其相連的水環(huán)境稱為土壤-水環(huán)境系統(tǒng),其中存在著大量的土壤固有微生物,并在表面存在生物膜,因為生物膜形成了隔離層,有機污染物在接觸到支撐生物膜的固體基底之前,必須首先到達并且穿過這個隔離層,這樣就強烈地改變礦物顆粒或基底的吸附行為,對吸附作用有重要的影響。
近年的研究表明,由于受污染影響,導(dǎo)致土壤中含有多環(huán)芳烴,沉積物中PAHs主要為原油污染以及工業(yè)或民用煤不完全燃燒所致,枯草芽孢桿菌對菲與苯并芘的吸附及生物降解研究,研究表明以枯草芽孢桿菌為接種微生物,對菲與苯并芘都可進行吸附或生物降解,48h液相PAHs濃度達到平衡時,微生物對菲消除了98%,對苯并芘消除85%;接種的樣品48h吸附等溫線均呈線形,能較好地符合線性方程;在接種微生物情況下,沉積物與土壤對菲和苯并芘吸附特征均發(fā)生較大變化,對菲的吸附量增大約35倍,而對苯并芘的吸附量卻降低了2/3左右;未接種微生物的土壤和沉積物對菲解吸率為20%,接種的樣品組為2.9%,而對苯并芘的解吸結(jié)果與菲相反,未接種的對照組為4%,接種的樣品組為3%。
近年的研究表明,由于受污染影響,導(dǎo)致土壤中含有多環(huán)芳烴,沉積物中PAHs主要為原油污染以及工業(yè)或民用煤不完全燃燒所致,枯草芽孢桿菌對菲與苯并芘的吸附及生物降解研究,研究表明以枯草芽孢桿菌為接種微生物,對菲與苯并芘都可進行吸附或生物降解,48h液相PAHs濃度達到平衡時,微生物對菲消除了98%,對苯并芘消除85%;接種的樣品48h吸附等溫線均呈線形,能較好地符合線性方程;在接種微生物情況下,沉積物與土壤對菲和苯并芘吸附特征均發(fā)生較大變化,對菲的吸附量增大約35倍,而對苯并芘的吸附量卻降低了2/3左右;未接種微生物的土壤和沉積物對菲解吸率為20%,接種的樣品組為2.9%,而對苯并芘的解吸結(jié)果與菲相反,未接種的對照組為4%,接種的樣品組為3%。
如果您對“枯草芽孢桿菌的作用有哪些?”存在任何疑問?或了解文中產(chǎn)品最新價格。
歡迎來電咨詢:15303928500,或點擊此處咨詢有機肥發(fā)酵專業(yè)技術(shù)人員。
上一篇:如何判別枯草芽孢桿菌的優(yōu)劣
下一篇:枯草芽孢桿菌如何使用
猜你喜歡
各種觀點

熱門排行
精彩圖文
-
 利用有機肥發(fā)酵劑發(fā)酵堆肥的方法詳解之所以要學(xué)習(xí)利用有機肥發(fā)酵劑發(fā)酵堆肥的方法,是因為堆肥自然發(fā)酵需要較長時間,這就影響了發(fā)酵效率,占用較大發(fā)酵場地,限制了分批循環(huán)發(fā)酵時的
利用有機肥發(fā)酵劑發(fā)酵堆肥的方法詳解之所以要學(xué)習(xí)利用有機肥發(fā)酵劑發(fā)酵堆肥的方法,是因為堆肥自然發(fā)酵需要較長時間,這就影響了發(fā)酵效率,占用較大發(fā)酵場地,限制了分批循環(huán)發(fā)酵時的 -
 有機肥發(fā)酵劑你真的了解嗎?有機肥發(fā)酵劑能夠分解蛋白質(zhì)、纖維素、半纖維素、木質(zhì)素等,并將細菌、真菌等復(fù)合而成。有效活菌數(shù)含量高,降解能力強,同時能夠達到升溫、除臭、
有機肥發(fā)酵劑你真的了解嗎?有機肥發(fā)酵劑能夠分解蛋白質(zhì)、纖維素、半纖維素、木質(zhì)素等,并將細菌、真菌等復(fù)合而成。有效活菌數(shù)含量高,降解能力強,同時能夠達到升溫、除臭、 -
 有機肥發(fā)酵劑如何使用有機肥發(fā)酵劑也稱為生物有機肥菌種,用于把有機固體廢物經(jīng)發(fā)酵、除臭和完全腐熟后加工而成有機肥料。本文來聊一聊有機肥發(fā)酵劑怎樣使用,有哪些功
有機肥發(fā)酵劑如何使用有機肥發(fā)酵劑也稱為生物有機肥菌種,用于把有機固體廢物經(jīng)發(fā)酵、除臭和完全腐熟后加工而成有機肥料。本文來聊一聊有機肥發(fā)酵劑怎樣使用,有哪些功 -
 有機肥發(fā)酵劑在不同發(fā)酵原料上的應(yīng)用有機肥按照生產(chǎn)原料不同可分為人糞尿、廄肥、堆肥、綠肥、餅肥、沼氣肥等。針對不同有機肥生產(chǎn)原料所采用的發(fā)酵方法也略有不同,具體來學(xué)習(xí)下有機
有機肥發(fā)酵劑在不同發(fā)酵原料上的應(yīng)用有機肥按照生產(chǎn)原料不同可分為人糞尿、廄肥、堆肥、綠肥、餅肥、沼氣肥等。針對不同有機肥生產(chǎn)原料所采用的發(fā)酵方法也略有不同,具體來學(xué)習(xí)下有機 -
 有機肥發(fā)酵劑作用有哪些有機肥發(fā)酵劑由能夠分解禽畜糞便的芽孢桿菌、酵母菌、乳酸菌、放線菌等80多種菌及代謝物組成。能夠分解蛋白質(zhì)、粗纖維,同時能夠達到升溫、除臭、
有機肥發(fā)酵劑作用有哪些有機肥發(fā)酵劑由能夠分解禽畜糞便的芽孢桿菌、酵母菌、乳酸菌、放線菌等80多種菌及代謝物組成。能夠分解蛋白質(zhì)、粗纖維,同時能夠達到升溫、除臭、



